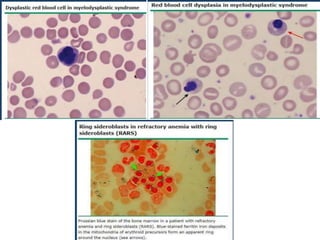
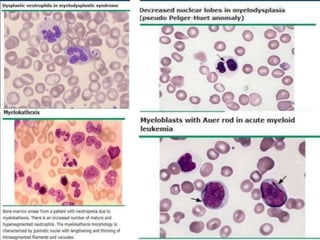

This document provides an overview of myelodysplastic syndrome (MDS). Key points include:
- MDS is a group of bone marrow disorders characterized by low blood cell counts, dysplastic changes in the bone marrow, and a risk of developing acute myeloid leukemia.
- It primarily affects older adults but can occur in younger patients as well. Risk factors include prior chemotherapy/radiation exposure, smoking, and certain genetic conditions.
- The disease involves malignant transformation of myeloid stem cells. Common genetic mutations impact DNA methylation and gene expression regulation.
- Patients present with anemia and related symptoms. Diagnosis involves blood and bone marrow tests showing dysplastic features. Prognosis depends on factors like blast percentage